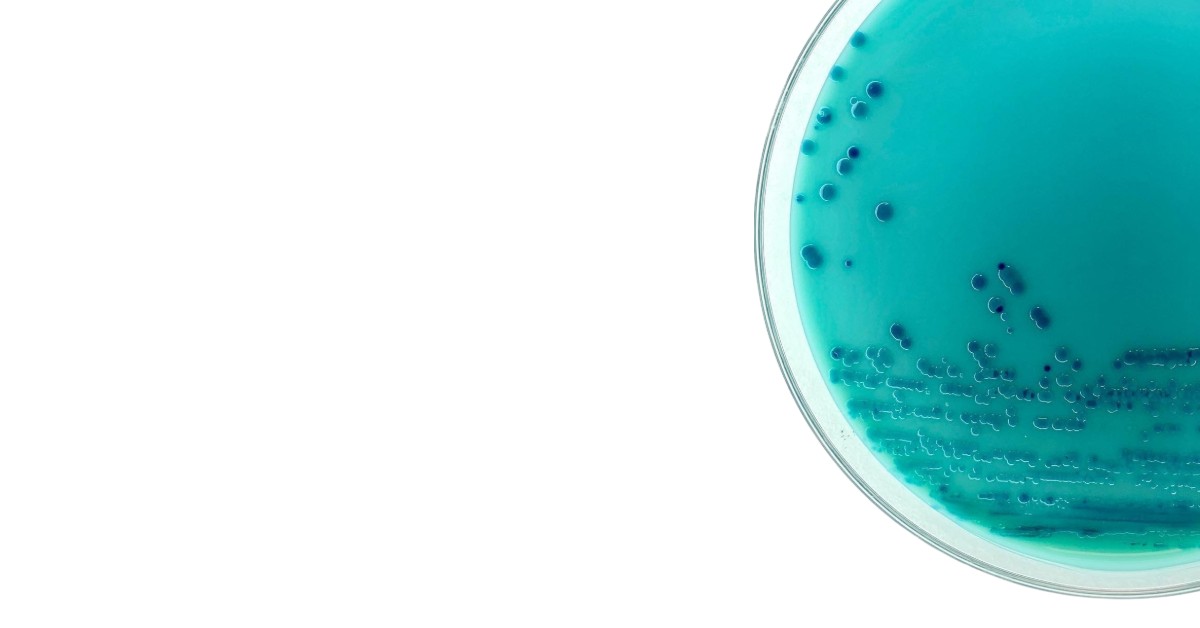
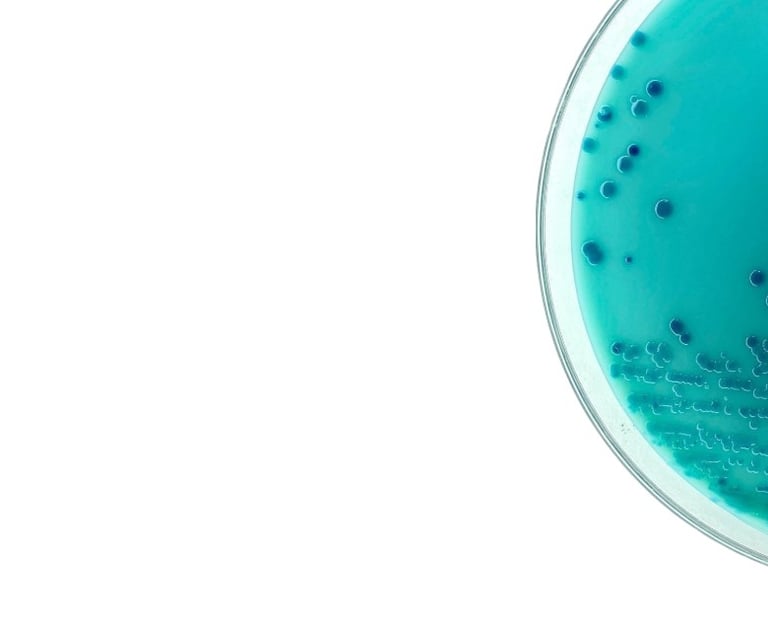

Science-led cleaning for
high-use environments
Programs are informed by applied chemistry, environmental assessment, and
disciplined process design.
Applicable environments
Amenity spaces
Boutique hospitality properties
High-traffic commercial and
Professional spaces and managed facilities that require structured, documented, and risk-informed environmental care.


We provide more than cleaning — we deliver long-term surface preservation, environmental stability, and operational safety. Every commercial space we manage is evaluated for material compatibility, traffic patterns, and environmental conditions to prevent damage before it happens
Reduce long-term repair and restoration costs
Evidence-based care strategies tailored to your facility
Maintain safety and liability standards for employees and clients
Protect finishes, textiles, and architectural surfaces from gradual wear
Our methodology evaluates material compatibility, microbial risk, environmental factors, and usage/operational patterns.
Veppa provides controlled environmental care for facilities where risk, exposure, and outcomes must be managed—not guessed. Programs are informed by applied microbiology, surface chemistry, and epidemiology fundamentals, and executed using professional-grade commercial agents aligned with established industry leaders.
Each environment is assessed based on microbial behavior, material compatibility, traffic patterns, and operational constraints to support consistent, verifiable risk reduction while preserving long-term surface integrity.
Learn more in Veppa Method. →
How outcomes are achieved
Veppa addresses this complexity through a structured system — the Veppa Method — which integrates structured assessment, environment-specific protocol design, controlled application, and ongoing verification.
This allows programs to remain effective over time while minimizing unnecessary intervention and material degradation.
Explore the Veppa Method →
This approach is informed by extensive field experience with professional chemical systems, hospitality environments, and applied environmental-health frameworks used where appropriate for commercial risk conditions.








Assessment
Controlled application
Verification
The Veppa Method is informed by infection-prevention and public-health frameworks adapted to real-world commercial environments.
Protocol design
How these situations are typically resolved
Examples of operational issues identified and corrected through chemistry, systems thinking, and protocol design in real environments.
Laundry Problems Misdiagnosed as Equipment Failure
In care facilities and hospitality environments, recurring laundry issues are often caused by chemical dosing imbalance and processes rather than equipment malfunction.
Correcting the handling process resolved the issue without equipment replacement, while reducing chemical overuse, water consumption, and fabric damage.
Outcome: operational stability without unnecessary cost.
Cross-surface Contamination from tool misuse
In offices and commercial spaces, improper textile and tool handling during cleaning can increase cross-surface contamination risk.
Redesigning surface and material handling protocols significantly reduces this exposure.
Outcome: safer environments through method, not intensity.
Chemistry & surface mismatch in commercial kitchens
In food service and hospitality kitchens, mismatches between cleaning agents and surface types lead to gradual surface damage and hygiene inefficiencies.
Matching chemistry, equipment, and surface use patterns corrects both issues.
Outcome: improved hygiene with reduced material stress.












Reduced microbial burden
Lower cross-contamination
risk
Improved environmental consistency
Verifiable results








Tailored for your workspace, our services are selected based on chemical composition, reactivity, material compatibility, and air flow and long-term impact.
Outcomes
Verification refers to operational logs, dwell-time discipline, inspection documentation, and (when used) internal cleanliness indicators—not pathogen identification.

SELECTION CRITERIA
APPLICATION LOGIC
PHYSICAL ALIGNMENT
Chemical Composition
Reactivity
Material Compatibility
Long-Term Impact
Advanced Disinfection
Applied Where Appropriate
Aligned with Modern Infection-Prevention Practices
Surface Reality
Material Behavior
Environmental Conditions
Our commercial programs are supported by a structured Property Intelligence File — a documented system that tracks supply usage, visit frequencies, inspection findings, material conditions, and service recommendations. This record ensures accountability, supports planning, and creates transparency across teams and stakeholders.
Improper surface care increases liability exposure and accelerates material degradation in repeated service environments. Our protocols are designed to reduce cumulative surface stress while maintaining hygienic performance.
Regulatory & Standards Alignment
Our commercial environmental care protocols are informed by evidence-based guidance from the Centers for Disease Control and Prevention (CDC) and principles supported by the Association for Professionals in Infection Control and Epidemiology (APIC), including:
• Cleaning prior to disinfection
• Use of EPA-registered disinfectants in accordance with label instructions
• Contact time adherence
• High-touch surface prioritization
• Surface compatibility to preserve cleanability
• Risk-stratified environmental hygiene frequency
Learn More About →Our Standards informed methodology
If we are entrusted with an environment, we are obligated to understand it.
CLEANING THROUGH SCIENCE
LED BY EXPERIENCE








Track documentation, operations, and performance in active environments.
Our commercial care approach mirrors facility service protocols used in controlled environments — museums, hospitality, and high-end offices. We combine risk assessment, operational governance, and monitoring systems to ensure compliance with professional standards and long-term asset preservation.
Initiate a Commercial Hygiene Review
Discover how our Commercial Care program protects both your environment and your investment.


